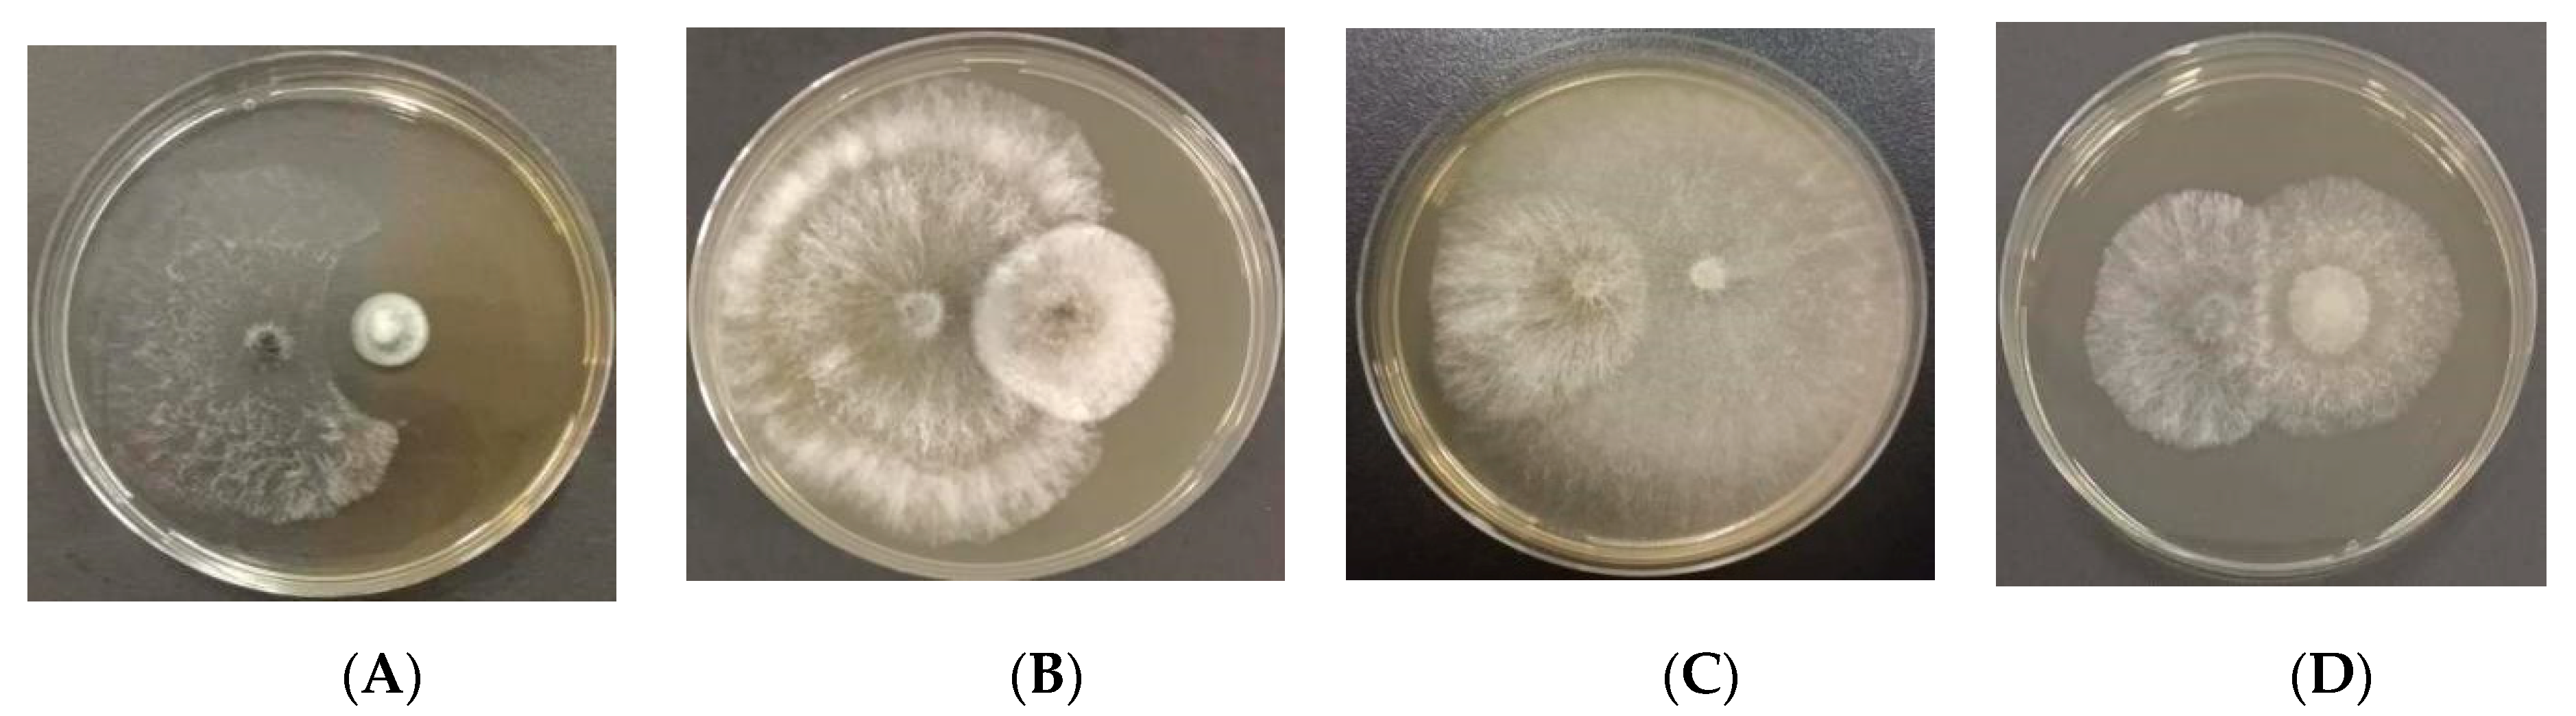
Jof 10 00212 g014
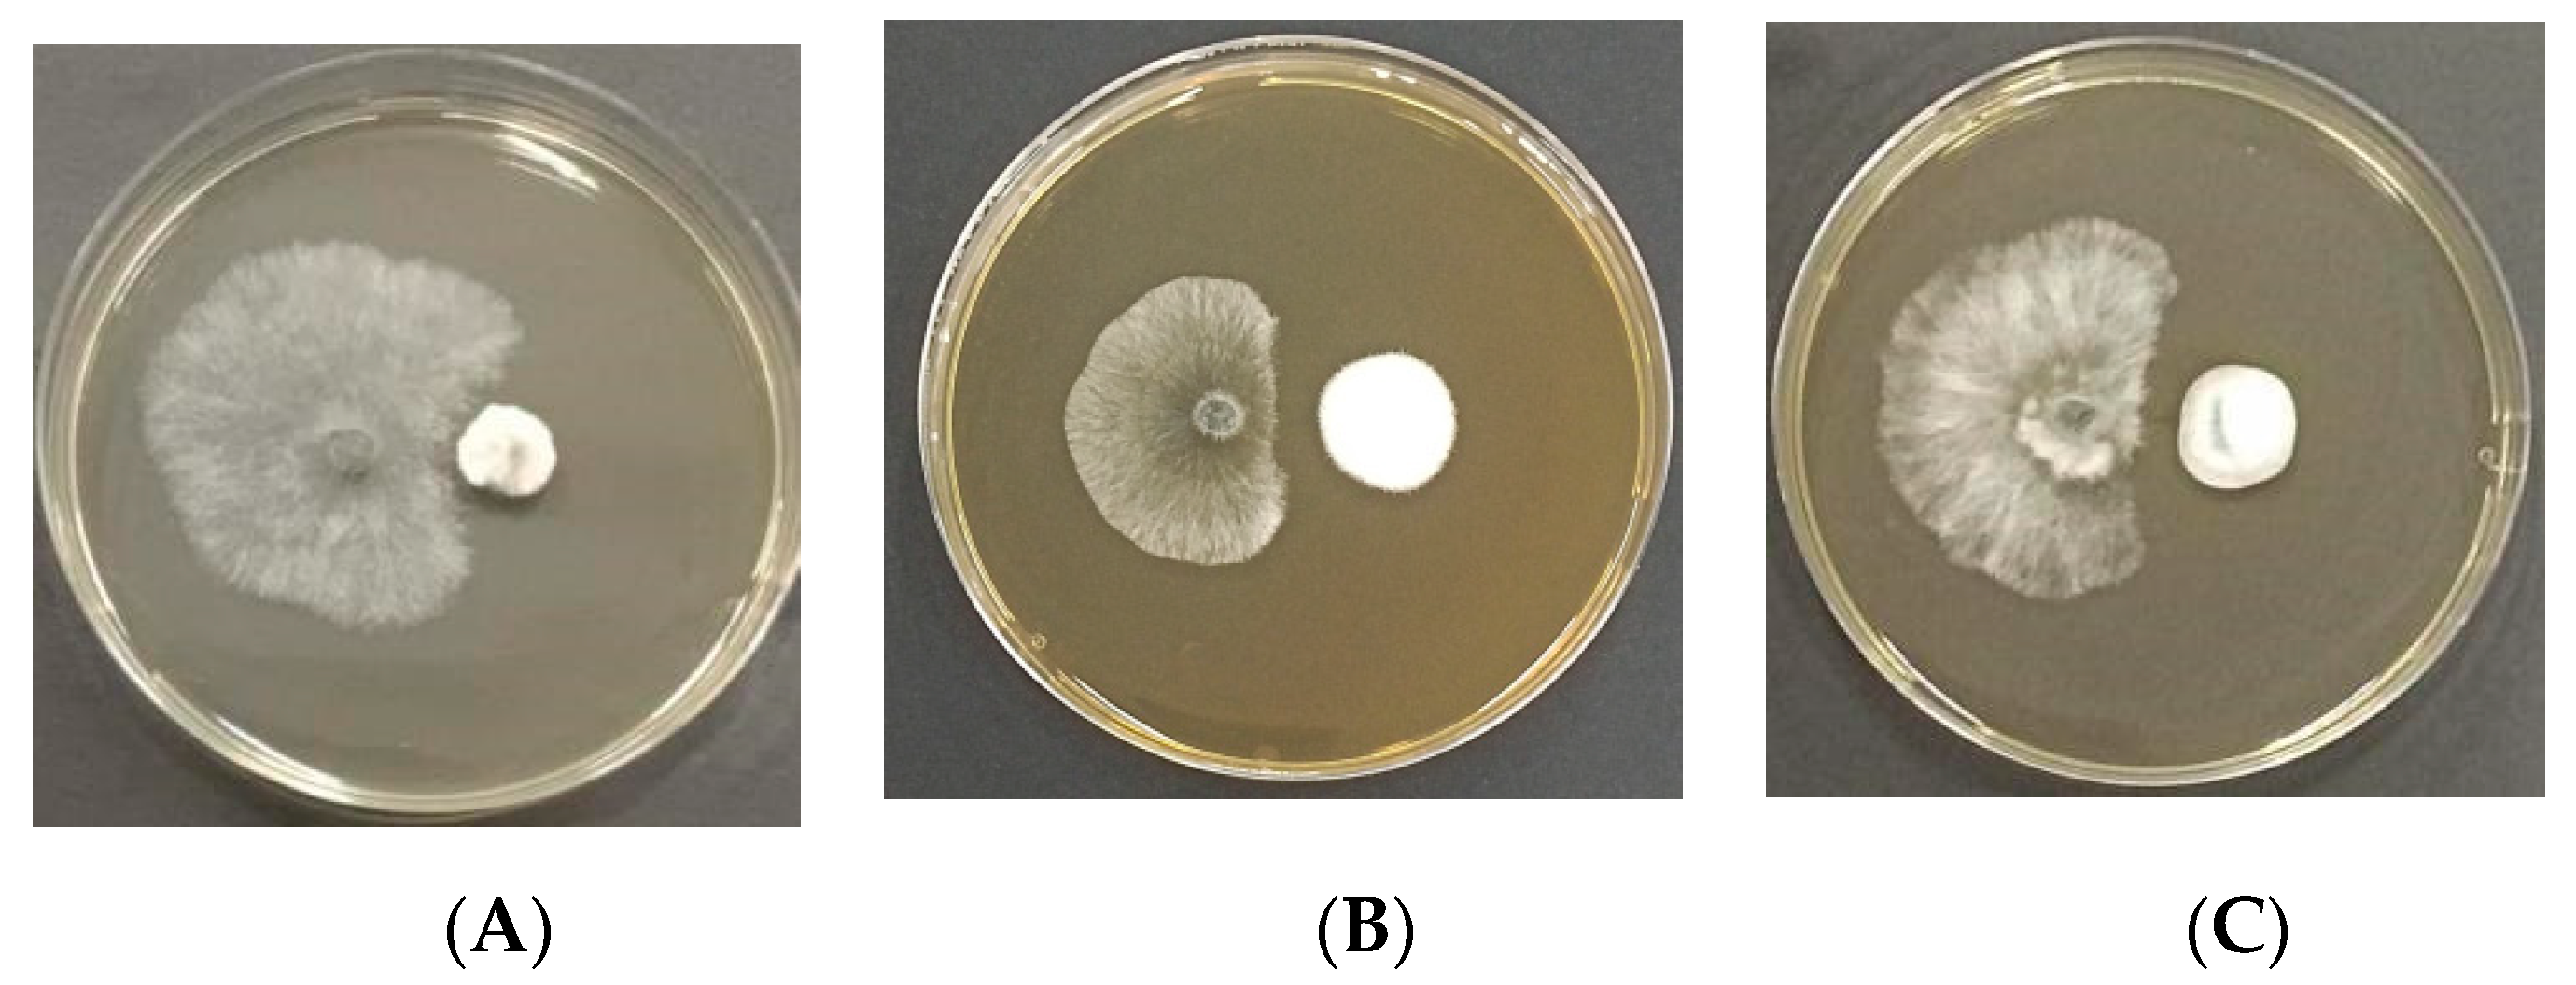
Jof 10 00212 g015

Diversity, Community Structure, and Antagonism of Endophytic Fungi from Asymptomatic and Symptomatic Mongolian Pine Trees
Abstract
1. Introduction
2. Materials and Methods
2.1. Study Sites and Sample Collection
2.2. Culture-Based Isolation and Molecular Identification
2.3. High-Throughput Sequencing
2.3.1. DNA Extraction, Amplification of ITS1 Region, and Sequencing
2.3.2. Preprocessing and Analysis of ITS1 Sequences
2.4. Antagonism Assay
2.5. Co-Culture Experiments with Preferential Placement of Endophytic Fungi
2.6. Preparation of Antagonistic Endophytic Fungal Fermentation Broth
2.7. Inoculation
3. Results
3.1. Isolation and Identification of Endophytic Fungi from Mongolian Pine
3.2. HTS Analysis of Endophytic Fungal Community of Mongolian Pine
3.2.1. Analysis of Endophytic Fungal Community Composition of Mongolian Pine
3.2.2. Alpha Diversity of Endophytic Fungal Community in Mongolian Pine
3.2.3. Beta Diversity of Endophytic Fungal Community in Mongolian Pine
3.2.4. LEfSe Analysis of Endophytic Fungal Community in the Shoots of Asymptomatic and Symptomatic Mongolian Pine
3.2.5. Functional Prediction of Endophytic Fungal Community in Mongolian Pine
3.3. In Vitro Study: Antagonism Assay
3.4. Co-Culture Experiment with Preferential Placement of Pe. fructuariae-cellae
3.5. Greenhouse Inoculation Experiment
4. Discussion
4.1. Endophytic Fungi Detected by Culture-Based Isolation and HTS Method
4.2. Endophytic Fungi Community in Different Tissues among Asymptomatic and Symptomatic Mongolian Pine
4.3. Antagonism Assay In Vitro and In Vivo
Supplementary Materials
Author Contributions
Funding
Institutional Review Board Statement
Informed Consent Statement
Data Availability Statement
Acknowledgments
Conflicts of Interest
References
- Kang, H.Z.; Zhu, J.J.; Xu, M.L. Study on water physiological properties of the artificially-planned saplings of Pinus sylvestris var. mongolica in the Horqin sand land. Arid Zone Res. 2007, 24, 15–22. [Google Scholar] [CrossRef]
- Xiang, C.T.; Yuan, S.Z.; Meng, F.R.; Jiang, J.Q. Study on diplodia tip blight of Pinus sylvestris var. mongolica. J. Northeast. For. Coll. 1981, 1–10, 129. [Google Scholar]
- Bußkamp, J. Schadenserhebung, Kartierung und Charakterisierung des “Diplodia-Triebsterbens“ der Kiefer, Insbesondere des Endophytischen Vorkommens in den Klimasensiblen Räumen und Identifikation von den in Kiefer (Pinus sylvestris) Vorkommenden Endophyten. [Damage Assessment, Mapping and Characterization of “Diplodia Tip Blight” of Pines, Especially the Endophytic Presence in Climate-Sensitive Areas and Identification of Pine Endophytes]. Ph.D. Thesis, Universität Kassel, Kassel, Germany, 2018. [Google Scholar]
- Bußkamp, J.; Langer, G.J.; Langer, E.J. Diplodia sapinea and fungal endophyte diversity in twigs of Scots pine (Pinus sylvestris) in Germany. Mycol. Progress. 2020, 19, 985–999. [Google Scholar] [CrossRef]
- Brodde, L.; Adamson, K.; Julio Camarero, J.; Castaño, C.; Drenkhan, R.; Lehtijärvi, A.; Luchi, N.; Migliorini, D.; Sánchez-Miranda, Á.; Stenlid, J. Diplodia tip blight on its way to the north: Drivers of disease emergence in northern Europe. Front. Plant Sci. 2019, 9, 414144. [Google Scholar] [CrossRef] [PubMed]
- Blumenstein, K.; Bußkamp, J.; Langer, G.J.; Langer, E.J.; Terhonen, E. The diplodia tip blight pathogen Sphaeropsis sapinea is the most common fungus in Scots pines’ mycobiome, irrespective of health status—A case study from Germany. J. Fungi 2021, 7, 607. [Google Scholar] [CrossRef]
- Oliva, J.; Boberg, J.; Stenlid, J. First Report of Sphaeropsis sapinea on Scots Pine (Pinus sylvestris) and Austrian Pine (P. nigra) in Sweden. New Dis. Rep. 2013, 27, 23. [Google Scholar] [CrossRef]
- Oliva, J.; Ridley, M.; Redondo, M.A.; Caballol, M. Competitive exclusion amongst endophytes determines shoot blight severity on pine. Funct. Ecol. 2021, 35, 239–254. [Google Scholar] [CrossRef]
- Terhonen, E.; Babalola, J.; Kasanen, R.; Jalkanen, R.; Blumenstein, K. Diplodia sapinea found as symptomless endophyte in Finland. Silva Fenn. 2021, 55, 10420. [Google Scholar] [CrossRef]
- Phillips, A.J.; Alves, A.; Abdollahzadeh, J.; Slippers, B.; Wingfield, M.J.; Groenewald, J.Z.; Crous, P.W. The Botryosphaeriaceae: Genera and species known from culture. Stud. Mycol. 2013, 76, 51–167. [Google Scholar] [CrossRef] [PubMed]
- Saikkonen, K.; Faeth, S.H.; Helander, M.; Sullivan, T.J. Fungal endophytes: A continuum of interactions with host plants. Ann. Rev. Ecol. Syst. 1998, 29, 319–343. [Google Scholar] [CrossRef]
- Alam, B.; Lǐ, J.; Gě, Q.; Khan, M.A.; Gōng, J.; Mehmood, S.; Yuan, Y.; Gǒng, W. Endophytic fungi: From symbiosis to secondary metabolitecommunications or vice versa? Front. Plant Sci. 2021, 12, 791033. [Google Scholar] [CrossRef] [PubMed]
- Vandenkoornhuyse, P.; Quaiser, A.; Duhamel, M.; Le Van, A.; Dufresne, A. The importance of the microbiome of the plant holobiont. New Phytologist. 2015, 206, 1196–1206. [Google Scholar] [CrossRef] [PubMed]
- Fabre, B.; Piou, D.; Desprez-Loustau, M.L.; Marçais, B. Can the emergence of pine Diplodia shoot blight in France be explained by changes in pathogen pressure linked to climate change? Glob. Chang. Biol. 2011, 17, 3218–3227. [Google Scholar] [CrossRef]
- Bosso, L.; Luchi, N.; Maresi, G.; Cristinzio, G.; Smeraldo, S.; Russo, D. Predicting current and future disease outbreaks of Diplodia sapinea shoot blight in Italy: Species distribution models as a tool for forest management planning. For. Ecol. Manag. 2017, 400, 655–664. [Google Scholar] [CrossRef]
- Slippers, B.; Wingfield, M.J. Botryosphaeriaceae as endophytes and latent pathogens of woody plants: Diversity, ecology and impact. Fungal Biol. Rev. 2007, 21, 90–106. [Google Scholar] [CrossRef]
- Sherwood, P.; Villari, C.; Capretti, P.; Bonello, P. Mechanisms of induced susceptibility to Diplodia tip blight in drought-stressed Austrian pine. Tree Physiol. 2015, 35, 549–562. [Google Scholar] [CrossRef] [PubMed]
- Blumenstein, K.; Bußkamp, J.; Langer, G.J.; Schlößer, R.; Parra Rojas, N.M.; Terhonen, E. Diplodia sapinea and associated endophytes in scots pine: Interactions and effect on the host under variable water content. Front. For. Glob. Chang. 2021, 4, 655769. [Google Scholar] [CrossRef]
- Peršoh, D. Factors shaping community structure of endophytic fungi—Evidence from the Pinus–Viscum-system. Fungal Divers. 2013, 60, 55–69. [Google Scholar] [CrossRef]
- Kovalchuk, A.; Mukrimin, M.; Zeng, Z.; Raffaello, T.; Liu, M.X.; Kasanen, R. Mycobiome analysis of asymptomatic and symptomatic Norway spruce trees naturally infected by the conifer pathogens Heterobasidion spp. Environ. Microbiol. Rep. 2018, 10, 532–541. [Google Scholar] [CrossRef]
- Chaudhary, P.; Chaudhary, A.; Bhatt, P.; Kumar, G.; Khatoon, H.; Rani, A.; Kumar, S.; Sharma, A. Assessment of soil health indicators under the influence of nanocompounds and Bacillus spp. in Field Condition. Front. Environ. Sci. 2022, 9, 769871. [Google Scholar] [CrossRef]
- Verma, S.K.; Sahu, P.K.; Kumar, K.; Pal, G.; Gond, S.K.; Kharwar, R.N.; White, J.F. Endophyte roles in nutrient acquisition, root system architecture development and oxidative stress tolerance. J. Appl. Microbiol. 2021, 131, 2161–2177. [Google Scholar] [CrossRef]
- Mejía, L.C.; Rojas, E.I.; Maynard, Z.; Van Bael, S.; Arnold, A.E.; Hebbar, P.; Samuels, G.J.; Robbins, N.; Herre, E.A. Endophytic fungi as biocontrol agents of Theobroma cacao pathogens. Biol. Control 2018, 46, 4–14. [Google Scholar] [CrossRef]
- Blumenstein, K.; Albrectsen, B.R.; Martín, J.A.; Hultberg, M.; Sieber, T.N.; Helander, M.; Witzell, J. Nutritional niche overlap potentiates the use of endophytes in biocontrol of a tree disease. BioControl 2015, 60, 655–667. [Google Scholar] [CrossRef]
- Pautasso, M.; Schlegel, M.; Holdenrieder, O. Forest health in a changing world. Microb. Ecol. 2015, 69, 826–842. [Google Scholar] [CrossRef] [PubMed]
- Witzell, J.; Martín, J.A.; Blumenstein, K. Ecological aspects of endophyte-based biocontrol of forest diseases. In Advances in Endophytic Research; Verma, V.C., Gange, A.C., Eds.; Springer: New Delhi, India, 2014; pp. 321–333. [Google Scholar] [CrossRef]
- Terhonen, E.; Kovalchuk, A.; Zarsav, A.; Asiegbu, F.O. Biocontrol potential of forest tree endophytes. In Endophytes of Forest Trees: Biology and Applications, Forestry Sciences; Pirttilä, A.M., Frank, A.C., Eds.; Springer International Publishing: Cham, Switzerland, 2018; pp. 283–318. [Google Scholar] [CrossRef]
- McMullin, D.R.; Nguyen, H.D.T.; Daly, G.J.; Menard, B.S.; Miller, J.D. Detection of foliar endophytes and their metabolites in Picea and Pinus seedling needles. Fungal Ecol. 2018, 31, 1–8. [Google Scholar] [CrossRef]
- Doyle, J.J. Isolation of plant DNA from fresh tissue. Focus 1990, 12, 13–15. [Google Scholar]
- White, T.J.; Bruns, T.; Lee, S.; Taylor, J. Amplification and direct sequencing of fungal ribosomal RNA genes for phylogenetics. In PCR Protocols: A Guide to Methods and Applications; Innis, M.A., Gelfand, D.H., Sninsky, J.J., White, T.J., Eds.; Academic Press: San Diego, CA, USA, 1990; Volume 18, pp. 315–322. [Google Scholar]
- Callahan, B.J.; McMurdie, P.J.; Rosen, M.J.; Han, A.W.; Johnson, A.J.; Holmes, S.P. DADA2: High-resolution sample inference from Illumina amplicon data. Nat. Methods 2016, 13, 581–583. [Google Scholar] [CrossRef]
- Bolyen, E.; Rideout, J.R.; Dillon, M.R.; Bokulich, N.A.; Abnet, C.C.; Al-Ghalith, G.A.; Alexander, H.; Alm, E.J.; Arumugam, M.; Asnicar, F.; et al. Reproducible, interactive, scalable and extensible microbiome data science using QIIME 2. Nat. Biotechnol. 2019, 37, 852–857. [Google Scholar] [CrossRef]
- Grice, E.A.; Kong, H.H.; Conlan, S.; Deming, C.B.; Davis, J.; Young, A.C.; Bouffard, G.G.; Blakesley, R.W.; Murray, P.R.; Green, E.D.; et al. Topographical and temporal diversity of the human skin microbiome. Science 2009, 324, 1190–1192. [Google Scholar] [CrossRef]
- Blumenstein, K. Endophytic Fungi in Elms: Implications for the Integrated Management of Dutch Elm Disease; Bangor University: Bangor, UK, 2015. [Google Scholar]
- Wu, H.; Liu, W.; Liu, L.Y.; Ren, Y.L. Isolation and identification of endophytic fungi in junggar hawthorn fruit and study of their antibacterial metabolites. Food Res. Dev. 2021, 42, 143–148. [Google Scholar] [CrossRef]
- Decourcelle, T.; Piou, D.; Desprez-Loustau, M.-L. Detection of Diplodia sapinea in Corsican pine seeds. Plant Pathol. 2015, 64, 442–449. [Google Scholar] [CrossRef]
- Lindahl, B.D.; Nilsson, R.H.; Tedersoo, L.; Abarenkov, K.; Carlsen, T.; Kjøller, R.; Kõljalg, U.; Pennanen, T.; Rosendahl, S.; Stenlid, J.; et al. Fungal community analysis by high-throughput sequencing of amplified markers—A user’s guide. New Phytologist. 2013, 199, 288–299. [Google Scholar] [CrossRef] [PubMed]
- Basili, M.; Perini, L.; Zaggia, L.; Luna, G.M.; Quero, G.M. Integrating culture-based and molecular methods provides an improved assessment of microbial quality in a coastal lagoon. Environ. Pollution. 2023, 334, 122140. [Google Scholar] [CrossRef]
- Langer, G.; Bressem, U.; Habermann, M. Diplodia-Triebsterben der Kiefer und endophytischer Nachweis des Erregers Sphaeropsis sapinea. [Diplodia Tip Blight of pines and the endophytic proof of the pathogen Sphaeropsis sapinea]. AFZ-Der Wald 2011, 11, 28–31. [Google Scholar]
- Luchi, N.; Oliveira Longa, C.M.; Danti, R.; Capretti, P.; Maresi, G. Diplodia sapinea: The main fungal species involved in the colonization of pine shoots in Italy. For. Pathol. 2014, 44, 372–381. [Google Scholar] [CrossRef]
- Terhonen, E.; Marco, T.; Sun, H.; Jalkanen, R.; Kasanen, R.; Vuorinen, M.; Asiegbu, F. The effect of latitude, season and needle-age on the mycota of Scots pine (Pinus sylvestris) in Finland. Silva Fenn. 2011, 45, 301–317. [Google Scholar] [CrossRef]
- Silva, A.C.; Henriques, J.; Diogo, E.; Ramos, A.P.; Bragança, H. First report of Sydowia polyspora causing disease on Pinus pinea shoots. For. Pathol. 2020, 50, e12570. [Google Scholar] [CrossRef]
- Pan, Y.; Ye, H.; Lu, J.; Chen, P.; Zhou, X.D.; Qiao, M.; Yu, Z.F. Isolation and identification of Sydowia polyspora and its pathogenicity on Pinus yunnanensis in Southwestern China. J. Phytopathol. 2018, 166, 386–395. [Google Scholar] [CrossRef]
- Leopold, D.R.; Busby, P.E. Host genotype and colonist arrival order jointly govern plant microbiome composition and function. Curr. Biol. 2020, 30, 3260–3266.e3265. [Google Scholar] [CrossRef] [PubMed]
- Molina, L.; Rajchenberg, M.R.; Errasti, A.; Voge, B.; Coetzee, M.P.A.; Aime, M.C.; Pildain, M.B. Sapwood mycobiome vary across host, plant compartment and environments in Nothofagus forests from Northern Patagonia. Mol. Ecol. 2023, 32, 6599–6618. [Google Scholar] [CrossRef] [PubMed]
- Lorenzini, M.; Cappello, M.S.; Perrone, G.; Logrieco, A.; Zapparoli, G. New records of Penicillium and Aspergillus from withered grapes in Italy, and description of Penicillium fructuariae-cellae sp. nov. Phytopathol. Mediterr. 2019, 58, 323–340. [Google Scholar]
- Li, J.X. Screening and Bioactivity Evaluation of Antagonistic Endophytic Fungi from Camellia sinensis. Master’s Thesis, Anhui Agricultural University, Hefei, China, 2022. [Google Scholar]

| Isolation Strain No. | Strains | Genbank Accession Number | HA | HB | HC | DA | DB | DC | Total | |||||||
|---|---|---|---|---|---|---|---|---|---|---|---|---|---|---|---|---|
| N | IF | N | IF | N | IF | N | IF | N | IF | N | IF | N | IF | |||
| EMD1 | Alternaria alternata | OR002004.1 | 2 | 2.86 | 3 | 2.78 | 2 | 3.51 | - | - | 2 | 2.33 | 5 | 10.42 | 14 | 3.23 |
| EMD2 | Alternaria infectoria | OR067375.1 | - | - | 2 | 1.85 | 1 | 1.75 | - | - | - | - | - | - | 3 | 0.69 |
| EMD3 | Alternaria seleniiphila | MK140693.1 | - | - | - | - | - | - | - | - | 4 | 4.65 | - | - | 4 | 0.92 |
| EMD4 | Alternaria solani | MN871615.1 | - | - | 1 | 0.93 | 1 | 1.75 | 1 | 1.56 | - | - | - | - | 3 | 0.69 |
| EMD5 | Alternaria sp. | MN096578.1 | - | - | - | - | - | - | - | - | 1 | 1.16 | 3 | 6.25 | 4 | 0.92 |
| EMD6 | Alternaria tenuissima | KM921667.1 | - | - | 1 | 0.93 | - | - | 1 | 1.56 | - | - | 1 | 2.08 | 3 | 0.69 |
| EMD7 | Aspergillus flavus | MH931826.1 | - | - | 1 | 0.93 | - | - | 5 | 7.81 | 4 | 4.65 | 2 | 4.17 | 12 | 2.77 |
| EMD8 | Aspergillus sp. | KR154911.1 | - | - | 1 | 0.93 | 1 | 1.75 | - | - | - | - | - | - | 2 | 0.46 |
| EMD9 | Botryotrichum murorum | MG770259.1 | - | - | 1 | 0.93 | - | - | - | - | - | - | - | - | 1 | 0.23 |
| EMD10 | Chaetomium globosum | MG885806.1 | 1 | 1.43 | - | - | - | - | - | - | - | - | - | - | 1 | 0.23 |
| EMD11 | Chromolaenicola clematidis | MT310601.1 | - | - | 1 | 0.93 | - | - | - | - | - | - | - | - | 1 | 0.23 |
| EMD12 | Cladosporium cladosporioides | OQ555096.1 | - | - | - | - | - | - | 3 | 4.69 | - | - | 1 | 2.08 | 4 | 0.92 |
| EMD13 | Cladosporium perangustum | MK722299.1 | - | - | - | - | 1 | 1.75 | - | - | - | - | - | - | 1 | 0.23 |
| EMD14 | Cladosporium sp. | MG975642.1 | 10 | 14.29 | 17 | 15.74 | 14 | 24.56 | 5 | 7.81 | 6 | 6.98 | 3 | 6.25 | 55 | 12.70 |
| EMD15 | Collariella bostrychodes | MH931826.1 | - | - | 1 | 0.93 | - | - | - | - | - | - | - | - | 1 | 0.23 |
| EMD16 | Coprinopsis atramentaria | KJ817302.1 | - | - | 1 | 0.93 | 1 | 1.75 | - | - | 1 | 1.16 | - | - | 3 | 0.69 |
| EMD17 | Curvularia senegalensis | MT476857.1 | - | - | - | - | - | - | - | - | 2 | 2.33 | - | - | 2 | 0.46 |
| EMD18 | Deniquelata sp. | ON705536.1 | - | - | - | - | - | - | - | - | 1 | 1.16 | - | - | 1 | 0.23 |
| EMD19 | Diplodia sapinea | MT763348.1 | 7 | 10.00 | 15 | 13.89 | 5 | 8.77 | 10 | 15.63 | 20 | 23.26 | 8 | 16.67 | 65 | 15.01 |
| EMD20 | Dothiorella gregaria | MH791151.1 | - | - | 1 | 0.93 | - | - | - | - | - | - | - | - | 1 | 0.23 |
| EMD21 | Fusarium fujikuroi | MH084746.1 | - | - | 2 | 1.85 | - | - | - | - | - | - | - | - | 2 | 0.46 |
| EMD22 | Fusarium sp. | OQ422002.1 | 2 | 2.86 | - | - | - | - | - | - | - | - | - | - | 2 | 0.46 |
| EMD23 | Fusarium verticillioides | OM956059.1 | - | - | 4 | 3.70 | - | - | - | - | - | - | - | - | 4 | 0.92 |
| EMD24 | Gregarithecium sp. DQD-2016a | KX364281.1 | - | - | 2 | 1.85 | 1 | 1.75 | - | - | 3 | 3.49 | - | - | 6 | 1.39 |
| EMD25 | Iodophanus carneus | MF161095.1 | - | - | 1 | 0.93 | - | - | - | - | - | - | - | - | 1 | 0.23 |
| EMD26 | Microsphaeropsis sp. | MN153956.1 | - | - | - | - | - | - | - | - | 1 | 1.16 | - | - | 1 | 0.23 |
| EMD27 | Neocamarosporium salicorniicola | MK809918.1 | - | - | - | - | - | - | 1 | 1.56 | - | - | - | - | 1 | 0.23 |
| EMD28 | Nothophoma quercina | ON527450.1 | 1 | 1.43 | - | - | - | - | - | - | - | - | - | - | 1 | 0.23 |
| EMD29 | Paracamarosporium hawaiiense | HM751092.1 | - | - | 1 | 0.93 | - | - | - | - | - | - | - | - | 1 | 0.23 |
| EMD30 | Paraphaeosphaeria sp. | GU985234.1 | - | - | - | - | - | - | 2 | 3.13 | - | - | - | - | 2 | 0.46 |
| EMD31 | Penicillium sp. | MK817609.1 | 4 | 5.71 | 5 | 4.63 | 13 | 22.81 | 10 | 15.63 | 11 | 12.79 | 2 | 4.17 | 45 | 10.39 |
| EMD32 | Penicillium fructuariae-cellae | OP703391.1 | - | - | 1 | 0.93 | 2 | 3.51 | - | - | 2 | 2.33 | 2 | 4.17 | 7 | 1.62 |
| EMD33 | Penicillium glabrum | OP681429.1 | 1 | 1.43 | - | - | - | - | - | - | - | - | - | - | 1 | 0.23 |
| EMD34 | Penicillium oxalicum | MT597864.1 | - | - | - | - | - | - | - | - | 1 | 1.16 | - | - | 1 | 0.23 |
| EMD35 | Periconia macrospinosa | MH345963.1 | 1 | 1.43 | - | - | - | - | - | - | - | - | - | - | 1 | 0.23 |
| EMD36 | Phialophora cyclaminis | MW447030.1 | - | - | - | - | - | - | - | - | 1 | 1.16 | - | - | 1 | 0.23 |
| EMD37 | Phoma sp. | MT366774.1 | - | - | - | - | - | - | 2 | 3.13 | - | - | - | - | 2 | 0.46 |
| EMD38 | Podospora australis | KX015765.1 | - | - | - | - | - | - | 3 | 4.69 | - | - | - | - | 3 | 0.69 |
| EMD39 | Podospora sp. | MW349896.1 | - | - | - | - | - | - | - | - | - | - | 1 | 2.08 | 1 | 0.23 |
| EMD40 | Preussia africana | OM743863.1 | - | - | - | - | - | - | - | - | 1 | 1.16 | - | - | 1 | 0.23 |
| EMD41 | Preussia persica | MW081300.1 | - | - | 1 | 0.93 | - | - | - | - | - | - | - | - | 1 | 0.23 |
| EMD42 | Preussia sp. | MT862280.1 | - | - | 7 | 6.48 | - | - | - | - | - | - | - | - | 7 | 1.62 |
| EMD43 | Rhizopus arrhizus | ON920727.1 | - | - | - | - | - | - | - | - | - | - | 3 | 6.25 | 3 | 0.69 |
| EMD44 | Sarocladium zeae | MZ969671.1 | - | - | 1 | 0.93 | - | - | - | - | - | - | - | - | 1 | 0.23 |
| EMD45 | Subramaniula cuniculorum | MT072073.1 | - | - | - | - | 1 | 1.75 | - | - | 2 | 2.33 | - | - | 3 | 0.69 |
| EMD46 | Sydowia polyspora | MN900630.1 | 32 | 45.71 | 25 | 23.15 | 10 | 17.54 | 8 | 12.50 | 14 | 16.28 | 5 | 10.42 | 94 | 21.71 |
| EMD47 | Taifanglania parvispora | KF719170.1 | - | - | - | - | - | - | - | - | 4 | 4.65 | - | - | 4 | 0.92 |
| EMD48 | Taifanglania sp. | KP143100.1 | - | - | - | - | - | - | 3 | 4.69 | - | - | - | - | 3 | 0.69 |
| EMD49 | Talaromyces amestolkiae | KT445914.1 | 3 | 4.29 | - | - | 1 | 1.75 | 3 | 4.69 | - | - | 1 | 2.08 | 8 | 1.85 |
| EMD50 | Talaromyces cecidicola | MN889416.1 | - | - | 1 | 0.93 | - | - | - | - | - | - | - | - | 1 | 0.23 |
| EMD51 | Talaromyces funiculosus | MT367866.1 | 1 | 1.43 | - | - | - | - | - | - | - | - | - | - | 1 | 0.23 |
| EMD52 | Talaromyces pseudofuniculosus | OP482383.1 | 3 | 4.29 | 9 | 8.33 | 3 | 5.26 | 4 | 6.25 | 3 | 3.49 | 9 | 18.75 | 31 | 7.16 |
| EMD53 | Torula fici | OW988181.1 | - | - | - | - | - | - | - | - | - | - | 2 | 4.17 | 2 | 0.46 |
| EMD54 | Tricharina sp. | MF055701.1 | 1 | 1.43 | - | - | - | - | - | - | - | - | - | - | 1 | 0.23 |
| EMD55 | Trichoderma afroharzianum | MT102402.1 | - | - | 1 | 0.93 | - | - | - | - | - | - | - | - | 1 | 0.23 |
| EMD56 | Trichoderma harzianum | KY495199.1 | - | - | 1 | 0.93 | - | - | 3 | 4.69 | - | - | - | - | 4 | 0.92 |
| EMD57 | Trichoderma sp. | MK871263.1 | 1 | 1.43 | - | - | - | - | - | - | 2 | 2.33 | - | - | 3 | 0.69 |
| Total | 70 | 100.00 | 108 | 100.00 | 57 | 100.00 | 64 | 100.00 | 86 | 100.00 | 48 | 100.00 | 433 | 100.00 | ||
| Pairs | R2 | p-Value |
|---|---|---|
| HA vs. DA | 0.16019719 | 0.005 |
| HB vs. DB | 0.40695618 | 0.001 |
| HC vs. DC | 0.07895605 | 0.115 |
| Isolation Strain No. | Strains | Visual Observation |
|---|---|---|
| EMD1 | Alternaria alternata | Pathogen superior |
| EMD2 | Alternaria infectoria | Pathogen superior |
| EMD3 | Alternaria seleniiphila | Pathogen superior |
| EMD4 | Alternaria solani | Pathogen superior |
| EMD5 | Alternaria sp. | Pathogen superior |
| EMD6 | Alternaria tenuissima | Pathogen superior |
| EMD7 | Aspergillus flavus | Equal growth capability |
| EMD8 | Aspergillus sp. | Endophyte superior |
| EMD9 | Botryotrichum murorum | Pathogen superior |
| EMD10 | Chaetomium globosum | Pathogen superior |
| EMD11 | Chromolaenicola clematidis | Pathogen superior |
| EMD12 | Cladosporium cladosporioides | Pathogen superior |
| EMD13 | Cladosporium perangustum | Pathogen superior |
| EMD14 | Cladosporium sp. | Pathogen superior |
| EMD15 | Collariella bostrychodes | Pathogen superior |
| EMD16 | Coprinopsis atramentaria | Pathogen superior |
| EMD17 | Curvularia senegalensis | Pathogen superior |
| EMD18 | Deniquelata sp. | Pathogen superior |
| EMD20 | Dothiorella gregaria | Pathogen superior |
| EMD21 | Fusarium fujikuroi | Pathogen superior |
| EMD22 | Fusarium sp. | Pathogen superior |
| EMD23 | Fusarium verticillioides | Pathogen superior |
| EMD24 | Gregarithecium sp. DQD-2016a | Pathogen superior |
| EMD25 | Iodophanus carneus | Pathogen superior |
| EMD26 | Microsphaeropsis sp. | Pathogen superior |
| EMD27 | Neocamarosporium salicorniicola | Pathogen superior |
| EMD28 | Nothophoma quercina | Pathogen superior |
| EMD29 | Paracamarosporium hawaiiense | Inhibition of pathogen growth |
| EMD30 | Paraphaeosphaeria sp. | Pathogen superior |
| EMD31 | Penicillium sp. | Pathogen superior |
| EMD32 | Penicillium fructuariae-cellae | Inhibition of pathogen growth |
| EMD33 | Penicillium glabrum | Pathogen superior |
| EMD34 | Penicillium oxalicum | Pathogen superior |
| EMD35 | Periconia macrospinosa | Pathogen superior |
| EMD36 | Phialophora cyclaminis | Pathogen superior |
| EMD37 | Phoma sp. | Equal growth capability |
| EMD38 | Podospora australis | Pathogen superior |
| EMD39 | Podospora sp. | Pathogen superior |
| EMD40 | Preussia africana | Pathogen superior |
| EMD41 | Preussia persica | Pathogen superior |
| EMD42 | Preussia sp. | Pathogen superior |
| EMD43 | Rhizopus arrhizus | Pathogen superior |
| EMD44 | Sarocladium zeae | Pathogen superior |
| EMD45 | Subramaniula cuniculorum | Pathogen superior |
| EMD46 | Sydowia polyspora | Pathogen superior |
| EMD47 | Taifanglania parvispora | Pathogen superior |
| EMD48 | Taifanglania sp. | Inhibition of pathogen growth |
| EMD49 | Talaromyces amestolkiae | Pathogen superior |
| EMD50 | Talaromyces cecidicola | Pathogen superior |
| EMD51 | Talaromyces funiculosus | Pathogen superior |
| EMD52 | Talaromyces pseudofuniculosus | Pathogen superior |
| EMD53 | Torula fici | Pathogen superior |
| EMD54 | Tricharina sp. | Endophyte superior |
| EMD55 | Trichoderma afroharzianum | Endophyte superior |
| EMD56 | Trichoderma harzianum | Endophyte superior |
| EMD57 | Trichoderma sp. | Pathogen superior |
| Isolation Strain No. | Strains | Inhibition Rate (%) | Isolated Tissue |
|---|---|---|---|
| EMD48 | Taifanglania sp. | (61.00 ± 1.73) b | DA |
| EMD29 | Paracamarosporium hawaiiense | (72.00. ± 4.00) a | HB |
| EMD32 | Penicillium fructuariae-cellae | (73.00. ± 4.62) a | HB and HC |
Disclaimer/Publisher’s Note: The statements, opinions and data contained in all publications are solely those of the individual author(s) and contributor(s) and not of MDPI and/or the editor(s). MDPI and/or the editor(s) disclaim responsibility for any injury to people or property resulting from any ideas, methods, instructions or products referred to in the content. |
© 2024 by the authors. Licensee MDPI, Basel, Switzerland. This article is an open access article distributed under the terms and conditions of the Creative Commons Attribution (CC BY) license (https://creativecommons.org/licenses/by/4.0/).
Share and Cite
Ren, N.; Wang, L.; You, C. Diversity, Community Structure, and Antagonism of Endophytic Fungi from Asymptomatic and Symptomatic Mongolian Pine Trees. J. Fungi 2024, 10, 212. https://doi.org/10.3390/jof10030212
Ren N, Wang L, You C. Diversity, Community Structure, and Antagonism of Endophytic Fungi from Asymptomatic and Symptomatic Mongolian Pine Trees. Journal of Fungi. 2024; 10(3):212. https://doi.org/10.3390/jof10030212
Chicago/Turabian StyleRen, Ninghong, Lei Wang, and Chongjuan You. 2024. "Diversity, Community Structure, and Antagonism of Endophytic Fungi from Asymptomatic and Symptomatic Mongolian Pine Trees" Journal of Fungi 10, no. 3: 212. https://doi.org/10.3390/jof10030212
APA StyleRen, N., Wang, L., & You, C. (2024). Diversity, Community Structure, and Antagonism of Endophytic Fungi from Asymptomatic and Symptomatic Mongolian Pine Trees. Journal of Fungi, 10(3), 212. https://doi.org/10.3390/jof10030212






